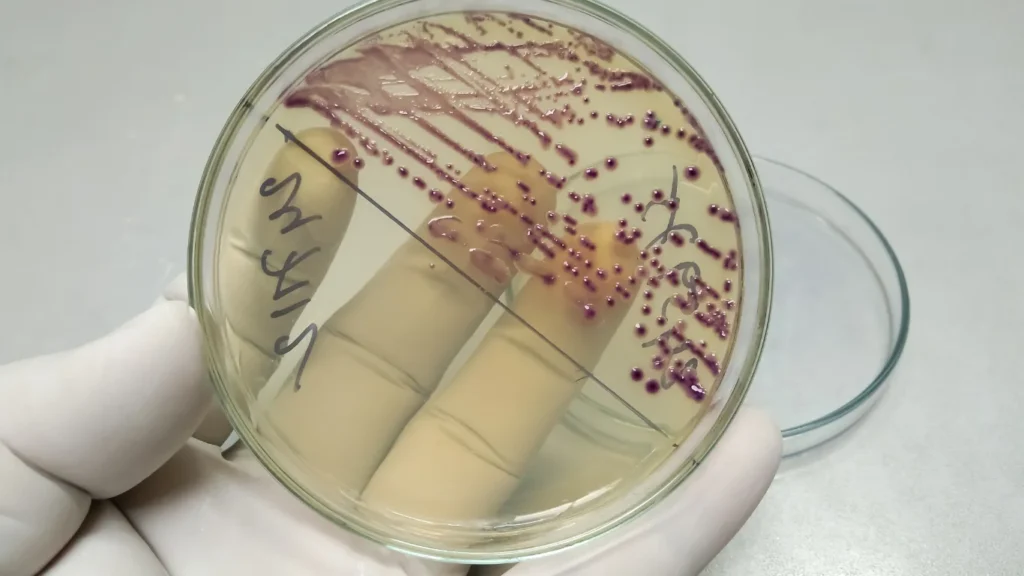

📍 124-125 Osborne Road, Pontypool, NP4 6LT
📍 123 Radipole Lane,Southill, Weymouth, DT4 9SS
Blood Tests

Private Blood Tests at Layanson Pharmacy
Blood tests play a vital role in assessing your overall health.
At Layanson Pharmacy, we offer a comprehensive range of private blood tests designed to check for infections, monitor organ function, assess nutrient levels, and detect certain genetic conditions. They’re among the most common and informative diagnostic tools available in modern healthcare.
What Can Blood Tests Detect?
Blood tests can help with:
Evaluating liver, kidney, thyroid, and heart function
Identifying nutritional deficiencies, such as low levels of iron, vitamin B12, or vitamin D
Monitoring blood cell counts – including red and white blood cells, platelets, and haemoglobin
Screening for infections, autoimmune disorders, and chronic conditions like anaemia, diabetes, or blood clotting issues
Supporting medication monitoring and identifying treatment effectiveness
Preparing for Your Test
When you book a blood test at Layanson Pharmacy, one of our healthcare professionals will guide you through any preparation steps. Depending on the specific test, you may be asked to:
Fast for 8-12 hours (only drinking water)
Pause certain medications, as instructed
Avoid alcohol or intense exercise before the test
Following these instructions ensures accurate results and prevents unnecessary delays.
The Testing Process
At Layanson Pharmacy, our blood test procedure is quick, safe, and handled by experienced staff:
Cleansing the area with antiseptic
Drawing blood from a vein in your arm using a sterile needle
Applying pressure and a plaster after collection to stop bleeding
You might feel a slight pinch or scratch during the process. If you’re nervous around needles or blood, please let our staff know – we’ll do our best to make you feel at ease.
Receiving Results
Some test results are available on the same day, while others may take a few days to a couple of weeks. We’ll let you know exactly when to expect them and how to receive them—whether through a phone call, email, or in-person consultation.
For tests that require follow-up such as HIV screening—supportive counselling and advice will be available.
Why Choose Layanson Pharmacy for Blood Testing?
We offer blood tests to:
Assess organ function (liver, kidneys, thyroid, heart)
Monitor ongoing medical treatments
Evaluate cardiovascular risk
Detect conditions such as diabetes, cancer, and HIV
Check your blood’s ability to clot properly
Your health and privacy are our top priorities. Whether you need routine screening, wellness checks, or diagnostic support, Layanson Pharmacy is here to help you stay in control of your health.
Have questions or ready to book a test?
Get in touch with Layanson Pharmacy today to arrange a convenient appointment with our team.
This profile is a detailed check of your liver and kidney function, your muscle and bone health, gout, iron levels, diabetes (HbA1c), and your full cholesterol profile.
The Thyroid function profile checks the general function of your Thyroid gland. It tests for the level of Thyroid Stimulating Hormone (TSH) & free T4 (Thyroxine)
Blood tests can detect Beta-HCG at lower levels than a urine tests, so this tests can help you confirm your pregnancy at the earliest possible date.
A high HbA1c is used to diagnose diabetes. It is particularly useful because it gives an indication of how often you have had abnormally high blood glucose levels over the previous 3 months
Check your Testosterone levels. In adult males, Testosterone is the hormone responsible for controlling sex drive, maintaining muscle mass, and producing sperm.
The test can indicate your risk of developing cardiovascular problems. High cholesterol levels can cause your arteries to be blocked, leading to coronary heart disease, a heart attack, or a stroke.
Calcium tests are used to diagnose and monitor different conditions that can affect bone, heart and kidneys.
hsCRP is a test that measures a protein that increases in the blood during inflammation. hsCRP tests are also used to predict the risk of heart conditions such as a heart attack.
Vitamin D is essential for your health and wellbeing. It helps regulate the amount of calcium and phosphate in the body which are needed to keep bones, teeth and muscles healthy. Low levels can cause a long list of problems including fatigue, bone & muscle pain, depression and more.
This extensive profile is perfect for any man or woman wishing to have a full body check-up and screening for potential underlying diseases or conditions.
Urgent Care
Urgent Care Services at Layanson Pharmacy When you’re feeling unwell and need fast, professional support, Layanson Pharmacy’s Urgent Care Clinic is here to help. We offer quick, walk-in access to...
Read More
Men’s Health
Men’s Health Matters at Layanson Pharmacy Throughout their 20s and 30s, men are often at the peak of their physical health. This is typically the stage where maturity develops and...
Read More
Ear Piercing
Layanson Pharmacy is now delighted to offer a professional ear piercing service for our customers. Your health and safety are our top priority, which is why all ear piercings are...
Read More